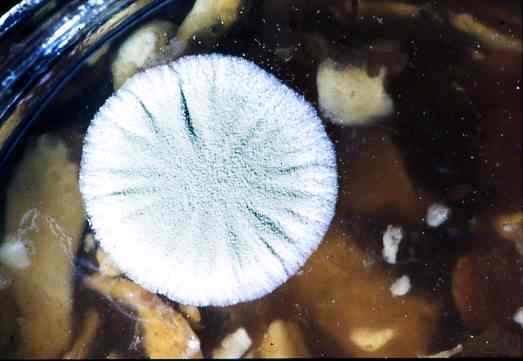

Goéland / 2 par Denis Gadenne (Voir toutes les photos CDC) |
|
|
        |
|
<<< Retour Bas de page > |
|
Où ? Quoi ? Comment ?
2 commentaires
Pour poster un commentaire sur cette photo, vous devez vous identifier... |
Copyright © 2006. Tous droits réservés